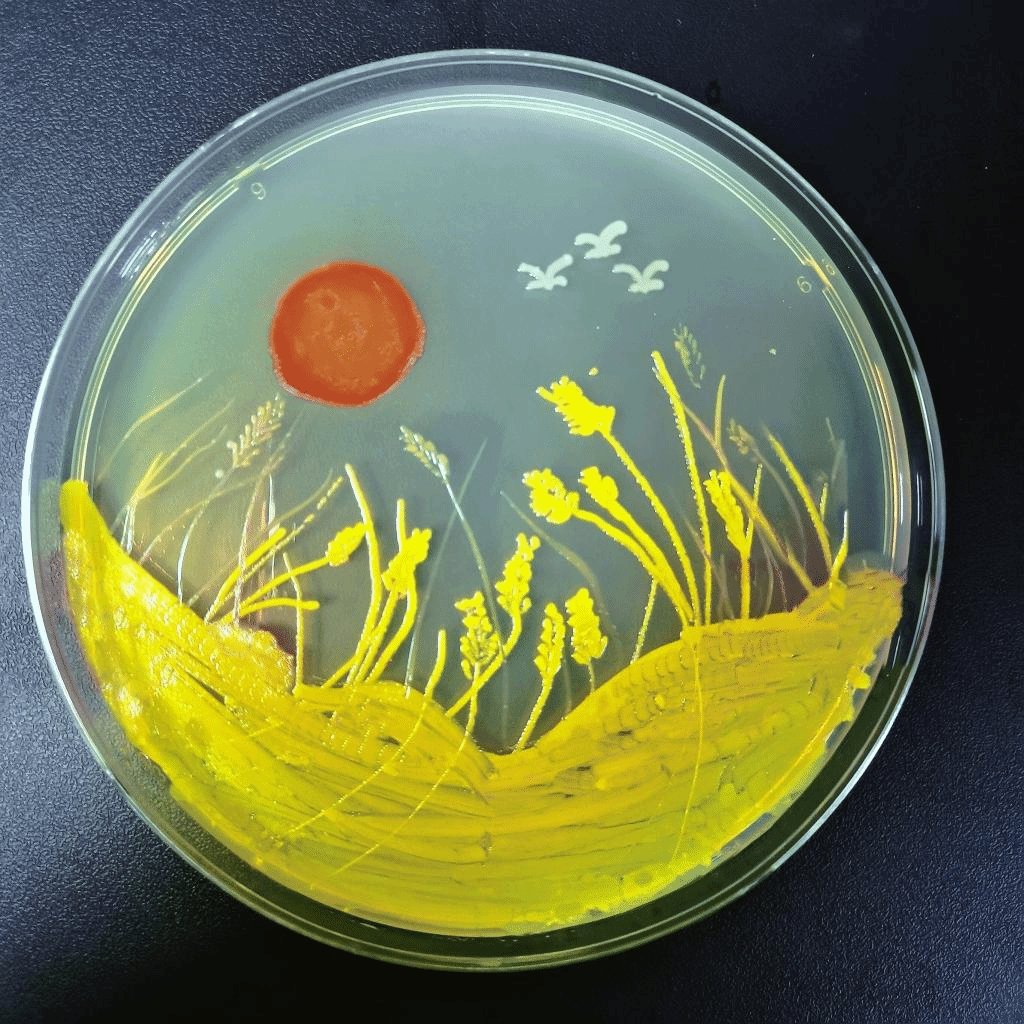

近日,湖北省第一届微生物培养皿艺术设计大赛落下帷幕,高春辉老师指导的《京篆碰撞》与吴一超老师指导的《醒狮与水中花》获得二等奖,罗雪松老师指导的《麦浪》获得三等奖。在历时5个月的比赛中,来自湖北省22所高校的544支队伍提交了839幅作品,经过初评、复赛两轮评审,评选出一等奖3项、二等奖8项、三等奖14项,优秀奖90项。
本次比赛由湖北省科学技术协会和华中农业大学共同主办,由我校国家农业生命科学技术科普基地承办,比赛以“科学探索‘微’之美,青春献礼二十大”为主题,旨在微生物作画,展示微生物多姿多彩的“微”美世界,促进科学、人文与艺术融合,涵养大学生审美情趣,激发大学生钻研生命科学的志趣。

二等奖作品《京篆碰撞》
二等奖作品《京篆碰撞》由nba88看球 农资2001班孙若琳同学协同队友来自环生2001的郝文琦、郝文琳同学制作,秉承“艺术与文化交融碰撞”的理念,展现中华传统文化的博大精深,彰显中国艺术的独特魅力,借此呼吁传承中华优秀传统文化。经过悉心设计,以灭菌细毛笔、粗端牙签、棉签为画笔,以粘质沙雷氏菌、转录不同基因的大肠杆菌等各色菌种为颜料,在特制渲染的LB培养基上创作而成。

二等奖作品《醒狮与水中花——醒狮·白昼》

二等奖作品《醒狮与水中花——醒狮·黑夜》

二等奖作品《醒狮与水中花——水中花》
由nba88看球 农资2001班余新韵同学及其队友制作的《醒狮与水中花》,寓意为醒狮:醒狮由黑盘到白盘表现狮子从黑暗到黎明的觉醒,同时也象征着逐渐站起来、强起来的中华民族,寄托着中华民族之伟大复兴的美好愿景,也为党的二十大顺利召开带去美好的祝愿。水中花:花于水中绽放,表现朴实无华,傲然顽强的生命力。柔美的线条与醒狮形成动静结合、刚柔并济的调和感,展现包容的艺术。
团队采用红色的粘质沙雷氏菌和转基因大肠杆菌创作两头狮子,一只以黑色为基底,表现沉睡中的狮子,一只以明黄色为背景,表示苏醒的狮子。由暗到明,表现狮子的觉醒,同时也象征着站起来的中华民族,寄托着中华民族之伟大复兴的美好愿景。还以金黄色葡萄球菌和酿酒酵母菌创作了水中花,是为了呼应水上梅花桩这一醒狮的表演项目。以蓝色培养基作为基地,白色和浅黄色的水中花仿佛有了在水中飘摇的灵动之感,与醒狮一柔一刚,一静一动,产生强烈的对比,以水中花寄予对未来生活的美好愿景。
三等奖作品《麦浪》
由nba88看球 农资2002班刘烨、董俊琦、许晶三位同学制作的《麦浪》,创意为“手中有粮,心中不慌”,阳光下茁壮成长的小麦,给人以愉悦与希望。制作过程为培养基的制备、接种与活化:按无菌操作分别将红(Escherichia coli)、黄(Staphylococcus aureus)、橙(Escherichia coli)、白(Bacillus sp.)四种菌种接种到培养基的四个区域。用封口膜将该培养皿密封,放入摇床培养一天。最后按无菌操作,用牙签和棉签蘸取菌液在培养基上进行作画。一共画三个培养基,保证结果的可重复性。
赛后,农资2001班的孙若琳这样谈到:“京剧是中华传统文化,以形传神,形神兼备,一字一句,娓娓道来;篆刻,是书法和镌刻结合的产物,也是汉字所特有的艺术形式。以京剧人物与篆刻文字为画面主体,是艺术的交融,也是文化的碰撞。这次微生物绘画比赛,我们在实践中了解微生物的生长过程,对微生物的结构特性有了进一步的学习。用微生物进行作画是我们之前没有接触过的,这个过程是困难的,但也是十分神秘、有趣的。这次比赛我们不仅收获了微生物相关专业知识,也更锻炼了团队合作意识,受益匪浅!”
农资2001班的余新韵这样说“从接到比赛通知到完成比赛作品,在一周不到时间内,虽然最终只要提交三个作品,但是我们团队画了几十个培养基,在最后清洗的过程中培养皿的盖子和底盘垒满了四张实验桌。一份耕耘,一份收获。在比赛中,我们不仅专注于绘画创作,也在各种菌落的培养中比较发现各种菌落在PDA和LB培养基上不同的生长状态还有菌落之间的共生抑或是拮抗作用。微生物培养基设计大赛,不但锻炼了我们的艺术创作能力,也培养了我们微生物培养相关方面的科学知识,是一个非常有意义的比赛。”
获奖名单


文字记者:许涛 余新韵 孙若琳
图片记者:孙若琳 余新韵 刘烨
南湖新闻网链接://news.nba88kq.com/2022/1208/65330.shtml